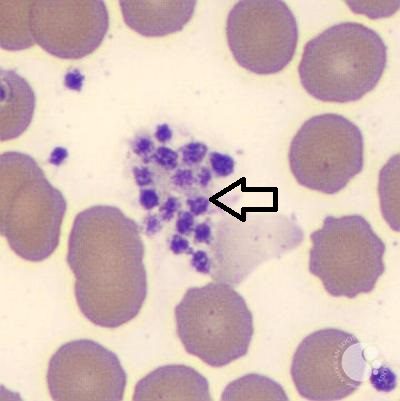
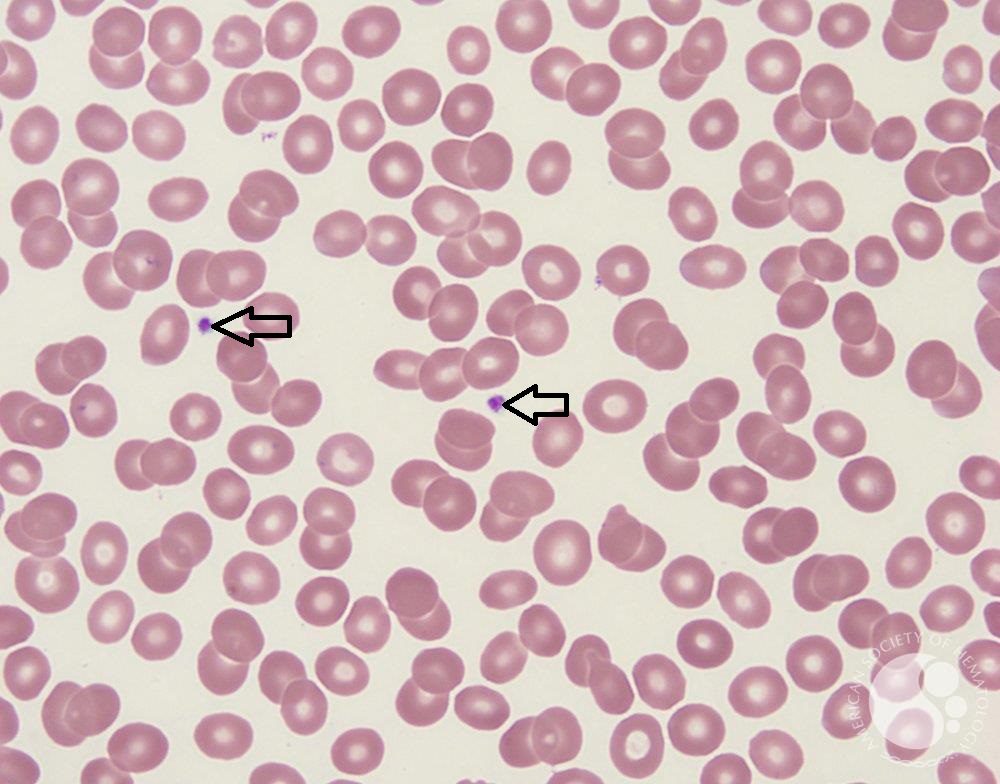

Are you ready to take the ASCP, AMT, or AAB Certification Exams for MLS, CLS & MLT? Tests your knowledge in Hematology Cell Identification and find out. Do it for fun or take this practice exam to help you prepare.

#1. Identify WBC inclusions inside the cell pointed
#2. Identify Elements Pointed

#3. Identify Pointed Structures

#4. Identify Cells Pointed

#5. Identify cell pointed

#6. Identify pointed structure
#7. Identify Structures Pointed

#8. Identify cell pointed

#9. Identify Cells Pointed

#10. Pointed cells is associated with what condition
Results







